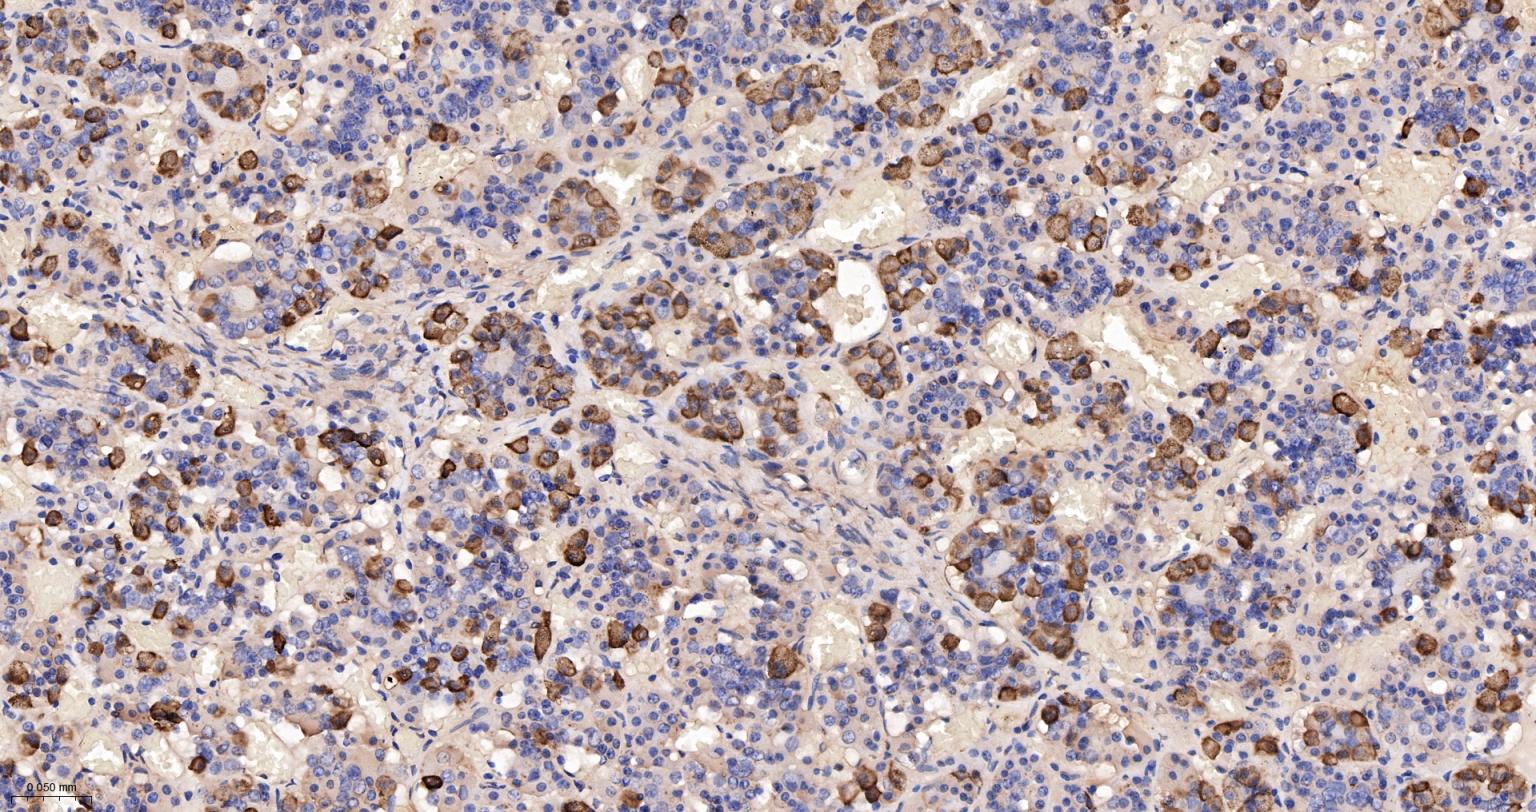
促肾上腺皮质激素重组兔单克隆抗体-bsm-60798R

ACTH Recombinant Rabbit mAb (一抗) - WB,IHC-P,IHC-F,IF | Bioss
Rrmab?兔单抗

货号:bsm-60798R
产品详情
相关标记
相关产品
相关文献
常见问题
概述
产品编号
bsm-60798R
产品类型
重组兔单抗
英文名称
ACTH Recombinant Rabbit mAb
中文名称
促肾上腺皮质激素重组兔单克隆抗体
英文别名
ACTH; CLIP; LPH; MSH; NPP; OBAIRH; POC; BE; Beta-LPH; Gamma-LPH; Pomc-1; Pomc1; alpha-MSH; alphaMSH; beta-MSH; gamma-MSH; Pomc2; COLI_BOVIN; POMC; Corticotropin-lipotropin; COLI_HUMAN; COLI_MOUSE; COLI_RAT;
抗体来源
Rabbit
免疫原
A synthesized peptide derived from human POMC: 110-180/267
亚型
IgG
性状
Liquid
纯化方法
affinity purified by Protein A
克隆类型
Recombinant
克隆号
A1H9
理论分子量
4.5/29 kDa
检测分子量
29 kDa
浓度
1mg/ml
储存液
PBS, Glycerol, BSA.
研究领域
SWISS
Gene ID
保存条件
Shipped at 4℃. Store at -20℃ for one year. Avoid repeated freeze/thaw cycles.
注意事项
This product as supplied is intended for research use only, not for use in human, therapeutic or diagnostic applications.
数据库链接
背景资料
This gene encodes a polypeptide hormone precursor that undergoes extensive, tissue-specific, post-translational processing via cleavage by subtilisin-like enzymes known as prohormone convertases. There are eight potential cleavage sites within the polypeptide precursor and, depending on tissue type and the available convertases, processing may yield as many as ten biologically active peptides involved in diverse cellular functions. The encoded protein is synthesized mainly in corticotroph cells of the anterior pituitary where four cleavage sites are used; adrenocorticotrophin, essential for normal steroidogenesis and the maintenance of normal adrenal weight, and lipotropin beta are the major end products. In other tissues, including the hypothalamus, placenta, and epithelium, all cleavage sites may be used, giving rise to peptides with roles in pain and energy homeostasis, melanocyte stimulation, and immune modulation. These include several distinct melanotropins, lipotropins, and endorphins that are contained within the adrenocorticotrophin and beta-lipotropin peptides. Mutations in this gene have been associated with early onset obesity, adrenal insufficiency, and red hair pigmentation. Alternatively spliced transcript variants encoding the same protein have been described. [provided by RefSeq, Jul 2008].

产品应用
| 应用 | 已检合格种属 | 预测种属 | 推荐稀释比例 |
|---|---|---|---|
| WB | Mouse, Rat | Human | 1:1000-5000 |
| IHC-P | Human, Rat | Mouse | 1:200-800 |
| IHC-F | Human, Rat | Mouse | 1:200-800 |
| IF | Human, Rat | Mouse | 1:200-800 |
交叉反应
交叉反应: Human, Mouse, Rat
相关产品
暂无相关产品
靶标
基因名
POMC
蛋白名
Pro-opiomelanocortin
亚基
Belongs to the POMC family.
亚细胞定位
Secreted.
组织特异性
ACTH and MSH are produced by the pituitary gland.
翻译后修饰
Specific enzymatic cleavages at paired basic residues yield the different active peptides.
O-glycosylated; reducing sugar is probably N-acetylgalactosamine.
O-glycosylated; reducing sugar is probably N-acetylgalactosamine.
疾病
Defects in POMC may be associated with susceptibility to obesity (OBESITY) [MIM:601665]. It is a condition characterized by an increase of body weight beyond the limitation of skeletal and physical requirements, as the result of excessive accumulation of body fat.
Defects in POMC are the cause of pro-opiomelanocortinin deficiency (POMCD) [MIM:609734]. Affected individuals present early-onset obesity, adrenal insufficiency and red hair.
Defects in POMC are the cause of pro-opiomelanocortinin deficiency (POMCD) [MIM:609734]. Affected individuals present early-onset obesity, adrenal insufficiency and red hair.
相似性
Belongs to the POMC family.
功能
ACTH stimulates the adrenal glands to release cortisol.
MSH (melanocyte-stimulating hormone) increases the pigmentation of skin by increasing melanin production in melanocytes.
Beta-endorphin and Met-enkephalin are endogenous opiates.
MSH (melanocyte-stimulating hormone) increases the pigmentation of skin by increasing melanin production in melanocytes.
Beta-endorphin and Met-enkephalin are endogenous opiates.
同靶标产品
相关文献
提示: 发表研究结果有使用 bsm-60798R 时请让我们知道,以便我们可以引用参考文章。作为回馈,资料提供者将获得我们送上的小礼品。